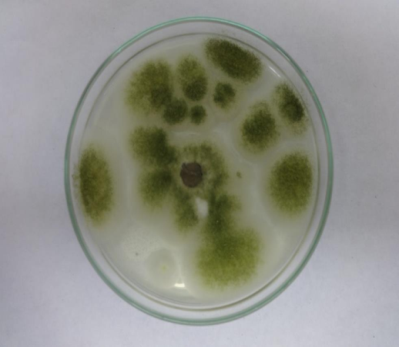

1Bioprocess Laboratory, Department of Biotechnology, Karpaga Vinayaga College of Engineering and Technology, Madhurantakam, Tamilnadu, India, 2Department of Biotechnology, Sri Venkateshwara College of Engineering, Erungattukottai, Tamilnadu, India.
Email: karthimicro2006@gmail.com
Received: 29 May, 2014 Revised and Accepted: 01 July, 2014
ABSTRACT
Objective: The idea behind this work is to investigate the possible improvement in nutritional values of agro industrial by products namely black gram husk (Vignamungo), yellow pigeon pea husk (Cajanuscajan) and black chick pea husk(Cicerarietinum) using Trichoderma viride a fungus over a period of 15 days.
Methods: The samples were analyzed for their proximate composition according to the standard methods of A.O.A.C.
Results: Substantial improvement was observed in the protein content for black gram husk and black chick pea husk. The crude fibre of the treated samples of black gram husk, black chick pea husk decreased when compared to the untreated. But there was a trivial decrease in the protein content and increase in crude fibre content for Yellow pigeon pea husk treated with Trichoderma viride than untreated. Ether extract was found to be reduced for all the three treated samples. Significant reduction in the cell wall content of the husk samples was observed.
Conclusion: Results of the study showed that fungal biodegradation of the agro industrial by-products can enhance their nutritional status. Using such by-products to feed cow can produce improved quantity of milk.
Keywords: Trichoderma viride, Black gram, Yellow pigeon pea, Black chick pea, Proximate analysis.
INTRODUCTION
The Indian livestock feed industry competes with other sectors for the consumption of conventional ingredients. This competition often pushes the prices of finished feed upwards. Agro industrial byproducts are abundant in India. Among the common ones are black gram husk, black chickpea husk and yellow pigeon pea husk. The possibility of using these by products for livestock has been explored, but with limited success due to processing costs. Black gram (Vignamungo), is one of the important pulses crop, grown throughout the country).India is the largest producer of Yellow pigeon pea (Cajanuscajan) contributing to around 85% i.e., 2530000 MT of the world total production. Chickpea or chana (Cicerarietinum) is another very important pulse crop that grows as a seed of a plant from the Leguminosae family. The world's total production of chickpeas hovers around 8.5 million metric tons annually and is grown over 10 million hectares of land. These three plants were selected on the basis of their abundant availability and cheaper cost rates. The shortage of feeds in general and protein in particular attracts the attention of many researchers to manipulate the unconventional sources of feeds [1]. Bioconversions are a process carried out by microorganisms to convert a compound into a product that has a chemical structure related or often called microbial transformation. Bioconversions in feed material can be made with fermentation technology. Fermentation technology is one alternative and inexpensive method to improve the nutritional value of agro byproducts when it is treated with fungi because it grows under room temperature and is much easier mode to perform with if it is a non- pathogenic strain [2].Fermentation with the fungus Trichoderma viride has been used in various substrates. This fungus lives on suitable substrates containing starch. Application of certain active enzymes and fermentation products (e.g. Trichodermaviride, Aspergillusoryzae, Bacillus subtilis) to ruminant feed has been shown to increase carbohydrate availability and fiber digestibility, which contribute to increased rate of weight gain and feed utilization efficiency [3]. Trichoderma viride is widely used as bio-control agent against several root pathogenic fungi throughout the world [4]. Trichoderma spp. is free living fungi that are highly interactive in root, soil foliar and environments. The major part of any husk is cellulose polymerase, hemi cellulose and lignin which can be used to domesticate animals and birds as well as for producing some of other microbial metabolites such as cellulolytic enzymes or ethanol. Microbial transformation could be done on these products to increase the nutritional values of the husks [5]. The major part of them is cellulose polymerase, hemi cellulose and lignin which can be used to domesticate animals and birds. Microorganisms of both aerobic and anaerobic sources are able to produce extra cellular enzymes to degrade macromolecules like starch, cellulose, hemicellulose, lignin and pectin of the plant cell wall as well as improve the protein content of husk and reduction in fiber composition of the substrates[6]. The advent of fungal biotechnology, with its inexpensive mode of application, has been used as a tool for the effective conversion of these wastes into useful products. Fungi can increase the protein and soluble sugars and reduce the complex carbohydrates of these wastes [7]. Fungi of the species of Trichoderma viride is often used for fermenting feeds. This fungus produces several enzymes such as protease, lipase, pectinase and cellulose. This study is conducted to evaluate the effect of Trichoderma viride treatment in solid state on chemical composition and nutritive values over feed ingredients. Also the study will be helpful for farmers to enrich the nutrient values of the feed ingredients just by inoculating it with the fungi which grows in room temperature over 10-15 days and will be cost effective.
MATERIALS AND METHODS
Purchase and treatment of feed stuffs
Sample collection
The husk samples such as black gram, black chick pea and yellow pigeon pea were collected from a commercial wholesale dealer atKanchipuram district near Tamilnadu.
Isolation and identification of Trichoderma viride
The fungus Trichoderma viride was isolated from the soil near Kanchipuram district and was raised in Potato Dextrose agar for green colonies. Visual observation on colony morphology for the identification of Trichoderma viride was performed using lacto phenolcotton blue dye [8].
Inoculating the husk samples with Trichoderma viride
Control
100 grams of black gram husks, yellow pigeon pea husks and black chick pea husks sample was weighed and moistened with distilled water at the rate of 30ml/100gm of sample [8].
Test sample
100 grams of black gram husks, yellow pigeon pea husks and black chick pea husks sample was weighed and moistened with distilled water at the rate of 30ml/100gm of sample and autoclaved. A 6mm cork borer was used to prepare mycelia discs from a 5 day old culture. After the sterilization process the sample was cooled down to room temperature and to the autoclaved sample Trichoderma viride inoculums were added each with 5discs of the inoculums.
Each inoculated sample was well mixed, labeled and incubated with an environment of 280C.Samples were stirred every three days under microaerophilic condition through a loose tightening of the mouth of the conical flask. At the end of the experimental period, the samples were oven dried at 800C for 24hrs to stop degradation process [8].
Analysis of the Nutritional content in the feed stuff
Proximate analysis
The samples were analyzed for their proximate composition according to the standard methods of A.O.A.C. (1990), in the department of animal nutrition at Tamilnadu Veterinary and Animal Sciences University [9].
Ash analysis
Ash analysis is performed with a dry silica crucible and a muffle furnace at a temperature of 600 degree Celsius for two hours to estimate the total amount of ash by utilizing the weight difference [9].
Fig. 1(a): Culture of Trichoderma viride.

Fig. 1(b): Microscopic view of Trichodermaviride
Ether extract analysis
Soxhlet apparatus is used to estimate amount of ether extract in the different samples. After the process is over the ether extract in the Soxhlet flask is transferred to a hot air oven for evaporating the petroleum ether and dried [9].
Cell wall components
These were determined by the method of Van Soest et al. (1991). By definition, NDF fraction includes lignin, cellulose and hemicellulose while ADF consists of cellulose and lignin. Hemicellulose content was estimated as the difference between NDF and ADF [9].
Statistical Analysis
Treatment means were separated using Duncan’s Multiple Range test at 5% level of probability.
RESULTS AND DISCUSSION
Isolation and Identification of Trichoderma viride
The black gram husk, black chickpea husk and yellow pigeon pea husk test samples were treated with Trichoderma viride in which notable physical change was observed after 15 days whereas no such change was observed in the control sample as shown in Fig. 2(a), (b), (c).
Inoculating Trichoderma viride with different husk samples

Fig. 2(a): Control and treated samples of black gram husk after 15 days

Fig. 2(b): Control and treated samples of black chick pea husk after 15days

Fig. 2(c): Control and treated sample of yellow pigeon pea after 15 days.
The parameters namely moisture content, crude protein, crude fiber, ether extract, total ash, NFE, NDF,ADF and hemicellulose contents were analyzed for control and treated samples. The obtained results are giveninthetable1. The above parameters were analyzed and moisture content significantly increased for all the samples. The crude protein content increased for black gram husk and black chick pea husk where as decreased for yellow pigeon pea. The crude fiber decreased for black gram husk and black chick pea husk where as increased for yellow pigeon pea. Ether extract decreased for all the treated samples.
Table 1: Effect of variation in fermentation period on the proximate analysis, NDF, ADF and hemicelluloses content of various husks
| S. No. | Sample | Moisture
Content (%) |
Crude
Protein (%) |
Crude
Fiber (%) |
Ether
Extract (%) |
Total
Ash(%) |
NFE
(%) |
NDF
(%) |
ADF
(%) |
Hemi
Cellulose (%) |
| 1. | BGHC | 10.25 | 14.64 | 22.35 | 1.41 | 4.04 | 57.56 | 57.38 | 43.51 | 13.87 |
| 2. | BGHT | 28.84 | 21.00 | 19.06 | 0.88 | 3.90 | 55.16 | 54.69 | 44.72 | 9.97 |
| 3. | YPPHC | 8.61 | 11.31 | 37.95 | 1.37 | 4.27 | 45.10 | 62.10 | 48.89 | 13.21 |
| 4. | YPPHT | 29.19 | 9.77 | 40.35 | 0.57 | 3.54 | 45.77 | 75.88 | 60.82 | 15.06 |
| 5. | BCPHC | 9.16 | 4.85 | 48.46 | 0.55 | 3.32 | 42.82 | 71.88 | 61.72 | 10.16 |
| 6. | BCPHT | 27.12 | 5.53 | 47.80 | 0.27 | 3.70 | 42.70 | 77.35 | 65.12 | 12.23 |
Effect of Nutritional content of the feed stuff by biodegradation:
The total ash content decreased for black gram husk and black chick pea husk where as increased for yellow pigeon pea. NFE decreased for black gram husk and black chickpea husk whereas increased for yellow pigeon pea. NDF decreased for black gram husk whereas increased for yellow pigeon pea and black chickpea. ADF content increased for black gram husk and black chick pea husk where as decreased for yellow pigeon pea. Among the treated samples Cajanuscajan had maximum moisture content (29.19%) and minimum for Cicerarietinum which is because of the action of Tricchodermaviride. In the crude protein analysis, Vignamungo showed maximum improvement in protein content. In Cicerarietinum there was least improvement whereas in Cajanuscajan there was decrease in protein content. The increase in crude protein especially during the first 10 days might have resulted from the fermentation by other substrates by the microbe used in this study. The growth of the organism lead to loss of nutrient, the enabling environment becomes depleted gradually[8].

Fig. 3: Effect of variation on proximate analysis on various husks
It was reported that 11.29% of crude protein content obtained whereas in untreated sample 8.40% was the result obtained. This work was done on juice waste mixture [10]. Incrude fibre analysis the fibre content decreased for Vignamungo and Cicerarietinum but for Cajanuscajan there was a slight increase. Other reports on reduction in crude fiber value were probably due to the activities of fungal enzymes which degraded the non-cellulosic wall polysaccharidesof rice husk [11]. The fat content decreased for all the three treated samples and was very high in Cajamuscajan. The total ash content decreased slightly for Vignamungo and was comparably low for Cajanuscajan but increased for Cicerarietinum. The NDF factor increased for Cajanuscajan and Cicerarietinum but decreased for Vignamungo. The rate of increase was very high for Cajanuscajan. It was reported that31.55% of NDF content obtained where as in untreated sample 34.30%wastheresult obtained [12].This work was done on juice waste mixture. In Vignamungo there was a decrease in nitrogen free extract and was very low level of decrease in Cicerarietinum. In the case of acid detergent fibre, Cajanuscajan showed maximum improvement whereas there was slight improvement in cicerarietinum. The difference between nitrogen free extract and crude fiber as a source of useful energy to animal is primarily of comparative digestibility. The hemicellulose content increased for Cajanuscajan and cicerarietinum where as it decreased for Vignamungo. With the cell wall component, the rate of neutral detergent, acid detergent and hemicelluloses loss is uneven in all the samples [13].

Fig. 4: Effect of variation on cell wall contents on various husks
CONCLUSION
The importance in feed diversification is very important to meet up with the growing needs of human population. Samples of three agro industrial by products namely Black gram husk (Vignamungo), Black chick pea husk (Cicerarietinum), Yellow pigeon pea husk (Cajanuscajan) were degraded with fungi Trichoderma viride to improve the nutritional content of the samples. Various parameters like moisture content, crude protein, crude fiber, ether extract, total ash, nitrogen free extract, NDF, ADF and hemicellulose were measured for the treated and untreated samples. Among the tested samples there was increase in moisture and ADF values. Thereby, there is increase in the nutritional aspect of the sample. The crude protein content is increased for Black gram husk and chick pea husk but decreased for Pigeon pea husk. The ash content increased for chick pea husk alone. The NFE content decreased for Black gram husk. This study has shown that nutritional improvement of husk sample is possible and the inclusion of its subsequently biodegraded product in animal feed can be pursued with expected better utilization. But further research is needed because in chickpea and black gram husks the crude protein increased whereas in the case of yellow pigeon pea husk the crude protein content decreased. There is no uniformity of mode of action and results which is being observed in the study. Also the study proves as Trichoderma viride is capable of improving the nutritional values in the husk samples. Therefore, from the present study, it is concluded that the nutritional values of the agro waste which could be used as a feed ingredient can be further enriched with the help of fungal treatment. This type of feed can be fed to cow and other livestock.
CONFLICT OF INTERESTS
Declared None
ACKNOWLEDGEMENT
We are thankful to our Director, Mrs. Meenakshi Annamalai for her constant support in carrying out the research work. We would also like to mention our sincere thanks to TANUVAS, Chennai for their support in carrying out the analysis involved in the research work.
REFERENCE